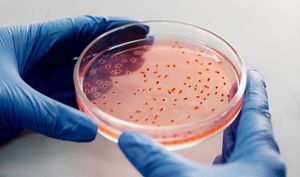
Firmă chineză de armament de control al creierului, interzisă în SUA

Etica tehnologiei de "control a creierului" din China
public
–
6 minute de lectură
Cercetătorii au argumentat că "neurocriminalitatea" și "piratarea creierului", reprezintă un risc major pentru "neurosecuritatea" individului, cum ar fi intimitatea și autonomia individuală.